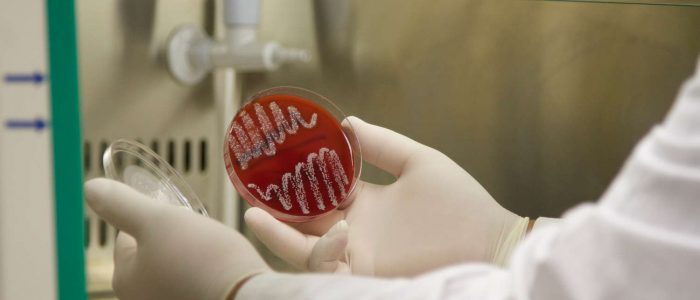

Il Laboratorio Analisi Cliniche e Microbiologiche “CASALE “ nasce nel 1981 nel rione Casale della città di Brindisi, è un centro che opera nel campo della diagnostica clinica , con settori di Chimica e Biochimica Clinica ,Biologia Molecolare,Ematologia, Indagini Ormonali, Coagulazione, Microbiologia e Medicina del Lavoro.
E’ accreditato con il S.S.R codice regionale 065078. Da Maggio 2020 ha avuto il riconoscimento X PLUS (eroga prestazione di Biologia Molecolare in regime di accreditamento).
Si e’ sempre contraddistinto per la puntuale applicazione delle normative, sia strutturali che organizzative. Il trasferimento nell’aprile 2013 nella nuova sede di Via XV Novembre 39/B ha determinato un nuovo slancio moderno e dinamico nell’esecuzione degli esami di laboratorio.
Il Laboratorio è strutturato in modalità “ OPEN SPACE “ per consentire una visione d’insieme del processo produttivo. Le moderne apparecchiature di cui il laboratorio dispone, consentono di processare un elevato numero di campioni rendendo possibile il completamento dell’intero processo di analisi, inclusa la refertazione finale al paziente, nell’ambito della stessa giornata.
A completamento della dotazione strumentale del laboratorio , è stata prevista l’informatizzazione dell’intero processo analitico, dall’accettazione alla refertazione degli esami chimico-clinici, garantendo la tracciabilità dei campioni durante tutte le fasi.
Qualità
Il Laboratorio di Analisi CASALE SRL ha applicato il Sistema di Gestione per la Qualità (SGQ) secondo il nuovo standard internazionale UNI EN ISO 9001:2015, conseguendo la certificazione con l’Ente “Det Norske Veritas” (DNV) nell’ 2006 e confermandola annualmente, Dal 2018 l’Ente certificatore è KIWA CERMET ITALIA .
In conformità a quanto previsto dal Sistema di Gestione della Qualità, la Direzione del Laboratorio e il personale tutto sono impegnati a garantire elevata efficacia ed efficienza dei servizi offerti, al fine di soddisfare le esigenze degli Utenti e degli stessi Medici curanti.
Tale obiettivo è costantemente perseguito attraverso:
- l’utilizzo di apparecchiature e strumentazione all’avanguardia;
- la continua formazione del Personale con la frequenza di corsi di aggiornamento;
- l’introduzione di nuovi test diagnostici;
- la riduzione dei tempi di attesa;
- la comunicazione tempestiva dei risultati “critici”;
- il rapporto umano e cordiale con l’Utente
- il rapporto professionale con i Medici.
Scopo del Laboratorio è quello di garantire ai servizi erogati quei requisiti di qualità che soddisfino a pieno le esigenze e le aspettative degli Utenti, e di migliorare continuamente gli standard di qualità.
Privacy e trattamento dei dati sensibili